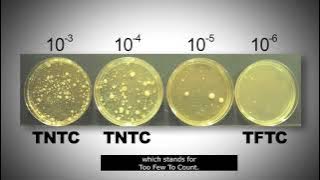
Standard plate count

30:31
30:31
Total Plate Count (Total Aerobic Bacterial Count)_A Complete Procedure (BAM, Ch-3)
Download Lagu Total Plate Count dapat kamu download secara gratis di DownloadLagu321, Stafaband, Metrolagu & Planetlagu. Untuk melihat detail lagu Total Plate Count klik salah satu tombol DOWNLOAD MP3 yang cocok, kemudian untuk link download Total Plate Count ada di halaman berikutnya. Download Total Plate Count mp3, Video 3gp & mp4. List download link Lagu MP3 Total Plate Count gratis and free streaming full album terbaru.
 30:31
30:31
 02:42
02:42
10:49
10:49
 04:57
04:57
 05:43
05:43
 30:41
30:41
 02:37
02:37
 03:04
03:04
 15:06
15:06
 07:07
07:07
© 2025 Gudanglagu321.cc